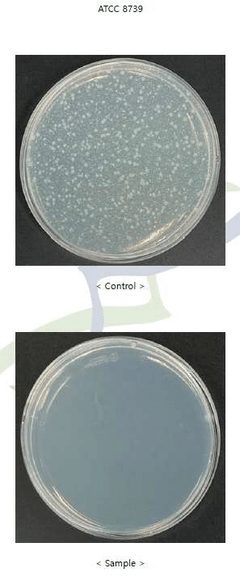

Antibacterial Coatings for Medical Textiles: An Analytical Approach
OCT 15, 20259 MIN READ
Generate Your Research Report Instantly with AI Agent
Patsnap Eureka helps you evaluate technical feasibility & market potential.
Medical Textile Antibacterial Coating Background & Objectives
The evolution of medical textiles has been marked by significant advancements in functionality, particularly in the realm of infection control. Healthcare-associated infections (HAIs) remain a persistent challenge in medical settings, with contaminated textiles serving as potential vectors for pathogen transmission. This has catalyzed extensive research into antibacterial coatings for medical textiles over the past three decades, evolving from simple chemical treatments to sophisticated nanotechnology-based solutions.
The historical trajectory of antibacterial textile coatings began with conventional approaches using silver compounds and quaternary ammonium salts in the 1980s. By the early 2000s, the field witnessed a paradigm shift with the integration of nanotechnology, enabling more durable and effective antimicrobial properties. Recent developments have focused on sustainable, biocompatible coatings that maintain efficacy while minimizing environmental impact and potential toxicity concerns.
Current technological trends indicate a movement toward multifunctional coatings that combine antibacterial properties with additional features such as self-cleaning capabilities, reduced biofilm formation, and enhanced durability through multiple washing cycles. The convergence of biotechnology and materials science has opened new avenues for biomimetic approaches and enzyme-based antibacterial systems that offer specificity in targeting pathogenic microorganisms.
The primary objective of this technical research is to comprehensively analyze existing antibacterial coating technologies for medical textiles, evaluating their efficacy, durability, safety profiles, and scalability potential. This analysis aims to identify technological gaps and opportunities for innovation in developing next-generation antibacterial coatings that address the limitations of current solutions.
Secondary objectives include assessing the compatibility of various coating technologies with different textile substrates commonly used in healthcare settings, examining the regulatory landscape governing antibacterial medical textiles, and evaluating the cost-effectiveness of implementation across various healthcare applications.
The research also seeks to explore emerging technologies that could revolutionize the field, including stimuli-responsive coatings that release antimicrobial agents on demand, sustainable bio-based alternatives to synthetic antimicrobials, and smart textiles that can monitor bacterial load and signal contamination. These advancements align with the broader healthcare industry trend toward preventive approaches to infection control and the growing emphasis on reducing antibiotic usage to combat antimicrobial resistance.
By establishing a clear understanding of the technological landscape and development trajectory, this research aims to provide strategic direction for future R&D investments and identify potential collaborative opportunities across industry, academia, and healthcare institutions.
The historical trajectory of antibacterial textile coatings began with conventional approaches using silver compounds and quaternary ammonium salts in the 1980s. By the early 2000s, the field witnessed a paradigm shift with the integration of nanotechnology, enabling more durable and effective antimicrobial properties. Recent developments have focused on sustainable, biocompatible coatings that maintain efficacy while minimizing environmental impact and potential toxicity concerns.
Current technological trends indicate a movement toward multifunctional coatings that combine antibacterial properties with additional features such as self-cleaning capabilities, reduced biofilm formation, and enhanced durability through multiple washing cycles. The convergence of biotechnology and materials science has opened new avenues for biomimetic approaches and enzyme-based antibacterial systems that offer specificity in targeting pathogenic microorganisms.
The primary objective of this technical research is to comprehensively analyze existing antibacterial coating technologies for medical textiles, evaluating their efficacy, durability, safety profiles, and scalability potential. This analysis aims to identify technological gaps and opportunities for innovation in developing next-generation antibacterial coatings that address the limitations of current solutions.
Secondary objectives include assessing the compatibility of various coating technologies with different textile substrates commonly used in healthcare settings, examining the regulatory landscape governing antibacterial medical textiles, and evaluating the cost-effectiveness of implementation across various healthcare applications.
The research also seeks to explore emerging technologies that could revolutionize the field, including stimuli-responsive coatings that release antimicrobial agents on demand, sustainable bio-based alternatives to synthetic antimicrobials, and smart textiles that can monitor bacterial load and signal contamination. These advancements align with the broader healthcare industry trend toward preventive approaches to infection control and the growing emphasis on reducing antibiotic usage to combat antimicrobial resistance.
By establishing a clear understanding of the technological landscape and development trajectory, this research aims to provide strategic direction for future R&D investments and identify potential collaborative opportunities across industry, academia, and healthcare institutions.
Healthcare Market Demand Analysis for Antimicrobial Textiles
The global healthcare antimicrobial textiles market has witnessed substantial growth in recent years, driven primarily by increasing healthcare-associated infections (HAIs) and growing awareness about infection control measures. Current market valuations indicate that the medical antimicrobial textiles sector reached approximately 7.1 billion USD in 2022, with projections suggesting a compound annual growth rate of 6.8% through 2030.
Hospital-acquired infections represent a significant healthcare burden worldwide, affecting roughly 1 in 25 hospitalized patients in developed countries and considerably more in developing regions. This persistent challenge creates a strong demand for preventive solutions, with antimicrobial textiles emerging as a critical intervention strategy.
The COVID-19 pandemic has dramatically accelerated market demand, creating unprecedented awareness about infection prevention across healthcare settings. This paradigm shift has expanded the application scope beyond traditional hospital environments to include outpatient facilities, nursing homes, and home healthcare settings. Market research indicates that hospital linens, surgical drapes, and healthcare worker uniforms constitute the largest application segments, collectively accounting for over 65% of market share.
Regional analysis reveals that North America currently dominates the market with approximately 38% share, followed by Europe at 29% and Asia-Pacific at 24%. However, the highest growth rates are being observed in emerging economies, particularly in India, China, and Brazil, where healthcare infrastructure development and increasing healthcare expenditure are creating new market opportunities.
Consumer behavior studies indicate that healthcare providers are increasingly willing to pay premium prices for textiles with proven antimicrobial efficacy, particularly those offering long-lasting protection and reduced environmental impact. This trend is supported by stringent infection control regulations and reimbursement policies that incentivize the adoption of preventive technologies.
Key market drivers include the rising geriatric population requiring extended healthcare, increasing surgical procedures worldwide, and growing concerns about antibiotic resistance. The latter is particularly significant, as antimicrobial textiles represent a non-pharmaceutical approach to infection control that does not contribute to antimicrobial resistance development.
Market segmentation analysis reveals distinct demand patterns across different healthcare settings. Acute care hospitals prioritize durability and broad-spectrum activity, while long-term care facilities emphasize comfort and cost-effectiveness. The ambulatory surgical centers segment is experiencing the fastest growth, driven by the global shift toward outpatient procedures and same-day surgeries.
Hospital-acquired infections represent a significant healthcare burden worldwide, affecting roughly 1 in 25 hospitalized patients in developed countries and considerably more in developing regions. This persistent challenge creates a strong demand for preventive solutions, with antimicrobial textiles emerging as a critical intervention strategy.
The COVID-19 pandemic has dramatically accelerated market demand, creating unprecedented awareness about infection prevention across healthcare settings. This paradigm shift has expanded the application scope beyond traditional hospital environments to include outpatient facilities, nursing homes, and home healthcare settings. Market research indicates that hospital linens, surgical drapes, and healthcare worker uniforms constitute the largest application segments, collectively accounting for over 65% of market share.
Regional analysis reveals that North America currently dominates the market with approximately 38% share, followed by Europe at 29% and Asia-Pacific at 24%. However, the highest growth rates are being observed in emerging economies, particularly in India, China, and Brazil, where healthcare infrastructure development and increasing healthcare expenditure are creating new market opportunities.
Consumer behavior studies indicate that healthcare providers are increasingly willing to pay premium prices for textiles with proven antimicrobial efficacy, particularly those offering long-lasting protection and reduced environmental impact. This trend is supported by stringent infection control regulations and reimbursement policies that incentivize the adoption of preventive technologies.
Key market drivers include the rising geriatric population requiring extended healthcare, increasing surgical procedures worldwide, and growing concerns about antibiotic resistance. The latter is particularly significant, as antimicrobial textiles represent a non-pharmaceutical approach to infection control that does not contribute to antimicrobial resistance development.
Market segmentation analysis reveals distinct demand patterns across different healthcare settings. Acute care hospitals prioritize durability and broad-spectrum activity, while long-term care facilities emphasize comfort and cost-effectiveness. The ambulatory surgical centers segment is experiencing the fastest growth, driven by the global shift toward outpatient procedures and same-day surgeries.
Current Antibacterial Coating Technologies & Limitations
The current landscape of antibacterial coating technologies for medical textiles encompasses several established approaches, each with distinct mechanisms of action and limitations. Metal-based coatings, particularly those utilizing silver nanoparticles, remain the most widely implemented solution due to their broad-spectrum antimicrobial efficacy. These coatings release silver ions that disrupt bacterial cell membranes and interfere with DNA replication. However, concerns regarding potential cytotoxicity, environmental accumulation, and the development of silver-resistant bacterial strains limit their long-term sustainability.
Quaternary ammonium compounds (QACs) represent another significant category, functioning through electrostatic interactions that disrupt bacterial cell membranes. While effective against a range of pathogens, QACs face challenges related to leaching during washing cycles, potentially reducing their longevity and efficacy over time. Additionally, emerging research indicates potential bacterial adaptation to QACs, raising concerns about long-term effectiveness.
Triclosan-based coatings, which inhibit bacterial fatty acid synthesis, have experienced declining popularity due to regulatory restrictions in several countries following evidence of endocrine disruption and environmental persistence. This regulatory landscape has accelerated the search for alternative technologies with improved safety profiles.
Chitosan-based coatings offer a promising natural alternative, leveraging the polysaccharide's inherent antimicrobial properties. While biocompatible and biodegradable, chitosan coatings typically demonstrate lower antimicrobial efficacy compared to synthetic alternatives and exhibit poor durability under repeated washing conditions, limiting their practical application in high-use medical textiles.
Enzyme-based technologies represent an emerging approach, utilizing enzymes that target specific components of bacterial cell walls. Though highly specific and environmentally friendly, these systems remain sensitive to environmental conditions and typically demonstrate shorter shelf lives than conventional antimicrobial agents.
A significant limitation across all current technologies is the challenge of achieving durable antimicrobial performance while maintaining textile comfort and breathability. Many coating processes alter the physical properties of the base textile, potentially compromising patient comfort and compliance. Furthermore, most existing technologies operate through release-killing mechanisms, creating concerns about diminishing efficacy over time and potential contribution to antimicrobial resistance.
The regulatory landscape presents additional challenges, with increasingly stringent requirements for safety documentation and efficacy validation. This regulatory environment has slowed the commercial adoption of novel coating technologies, creating a gap between laboratory innovations and market-ready solutions.
Quaternary ammonium compounds (QACs) represent another significant category, functioning through electrostatic interactions that disrupt bacterial cell membranes. While effective against a range of pathogens, QACs face challenges related to leaching during washing cycles, potentially reducing their longevity and efficacy over time. Additionally, emerging research indicates potential bacterial adaptation to QACs, raising concerns about long-term effectiveness.
Triclosan-based coatings, which inhibit bacterial fatty acid synthesis, have experienced declining popularity due to regulatory restrictions in several countries following evidence of endocrine disruption and environmental persistence. This regulatory landscape has accelerated the search for alternative technologies with improved safety profiles.
Chitosan-based coatings offer a promising natural alternative, leveraging the polysaccharide's inherent antimicrobial properties. While biocompatible and biodegradable, chitosan coatings typically demonstrate lower antimicrobial efficacy compared to synthetic alternatives and exhibit poor durability under repeated washing conditions, limiting their practical application in high-use medical textiles.
Enzyme-based technologies represent an emerging approach, utilizing enzymes that target specific components of bacterial cell walls. Though highly specific and environmentally friendly, these systems remain sensitive to environmental conditions and typically demonstrate shorter shelf lives than conventional antimicrobial agents.
A significant limitation across all current technologies is the challenge of achieving durable antimicrobial performance while maintaining textile comfort and breathability. Many coating processes alter the physical properties of the base textile, potentially compromising patient comfort and compliance. Furthermore, most existing technologies operate through release-killing mechanisms, creating concerns about diminishing efficacy over time and potential contribution to antimicrobial resistance.
The regulatory landscape presents additional challenges, with increasingly stringent requirements for safety documentation and efficacy validation. This regulatory environment has slowed the commercial adoption of novel coating technologies, creating a gap between laboratory innovations and market-ready solutions.
Current Antibacterial Coating Application Methods
01 Metal-based antibacterial coatings
Metal-based antibacterial coatings utilize metals such as silver, copper, and zinc that have inherent antimicrobial properties. These metals can be incorporated into coatings as nanoparticles, ions, or compounds that slowly release active agents to inhibit bacterial growth on surfaces. These coatings are particularly effective for medical devices, food processing equipment, and high-touch surfaces in healthcare settings, providing long-lasting protection against a broad spectrum of bacteria.- Metal-based antibacterial coatings: Metal-based antibacterial coatings utilize metals such as silver, copper, and zinc that have inherent antimicrobial properties. These metals can be incorporated into coatings as nanoparticles, ions, or compounds that slowly release active metal ions to inhibit bacterial growth. The mechanism typically involves disruption of bacterial cell membranes, interference with enzyme functions, or generation of reactive oxygen species. These coatings are particularly effective for medical devices, food processing equipment, and high-touch surfaces in healthcare settings.
- Polymer-based antibacterial coatings: Polymer-based antibacterial coatings incorporate antimicrobial agents within polymer matrices that can provide controlled release of active ingredients. These polymers can be natural or synthetic and may be functionalized to enhance their antibacterial properties. Some polymers themselves possess inherent antibacterial properties, while others serve as carriers for antibacterial agents. These coatings offer advantages such as durability, flexibility, and the ability to form thin films on various substrates, making them suitable for medical implants, textiles, and consumer products.
- Quaternary ammonium compound-based coatings: Quaternary ammonium compounds (QACs) are widely used in antibacterial coatings due to their broad-spectrum antimicrobial activity. These compounds contain positively charged nitrogen atoms that interact with negatively charged bacterial cell membranes, causing disruption and cell death. QAC-based coatings can be formulated to provide long-lasting protection against bacteria, fungi, and some viruses. They are commonly applied in healthcare settings, food processing facilities, and public spaces to reduce the spread of pathogens on surfaces.
- Nanoparticle-enhanced antibacterial coatings: Nanoparticle-enhanced antibacterial coatings utilize the unique properties of nanomaterials to combat bacterial growth. These nanoparticles, which can include metal oxides, carbon-based materials, and silica, provide increased surface area and enhanced reactivity compared to their bulk counterparts. The small size allows for better penetration into bacterial cells and more efficient release of antibacterial agents. These coatings can be engineered to provide multiple mechanisms of action simultaneously, reducing the likelihood of bacterial resistance development and extending the effective lifetime of the coating.
- Environmentally friendly and sustainable antibacterial coatings: Environmentally friendly antibacterial coatings utilize natural compounds and sustainable materials to provide antimicrobial protection without harmful environmental impacts. These coatings incorporate plant extracts, essential oils, enzymes, and biodegradable polymers that possess inherent antibacterial properties. The active ingredients in these coatings typically work through multiple mechanisms, including disruption of bacterial membranes, inhibition of enzyme activity, and interference with bacterial communication systems. These sustainable alternatives are increasingly important in consumer products, food packaging, and architectural applications where environmental impact is a concern.
02 Polymer-based antibacterial coatings
Polymer-based antibacterial coatings incorporate antimicrobial agents within polymer matrices that can be applied to various surfaces. These polymers can be designed to slowly release active ingredients or have inherent antibacterial properties through positively charged functional groups that disrupt bacterial cell membranes. The polymer matrix provides durability and controlled release of antibacterial agents, making these coatings suitable for long-term protection in diverse environments including healthcare facilities and consumer products.Expand Specific Solutions03 Natural compound-based antibacterial coatings
Antibacterial coatings derived from natural compounds utilize plant extracts, essential oils, and other biological materials with inherent antimicrobial properties. These environmentally friendly alternatives to synthetic chemicals include compounds like chitosan, plant polyphenols, and essential oils that can be incorporated into various coating formulations. These natural antibacterial agents offer advantages such as biodegradability, reduced toxicity, and consumer appeal for applications in food packaging, medical devices, and household items.Expand Specific Solutions04 Photocatalytic antibacterial coatings
Photocatalytic antibacterial coatings contain materials such as titanium dioxide that generate reactive oxygen species when exposed to light. These reactive species can destroy bacteria, viruses, and other microorganisms on the coated surface. The self-cleaning and continuous antibacterial action of these coatings make them particularly useful for outdoor applications, building materials, and areas with good light exposure. These coatings provide long-lasting protection without requiring frequent reapplication or chemical replenishment.Expand Specific Solutions05 Smart responsive antibacterial coatings
Smart responsive antibacterial coatings are designed to activate their antimicrobial properties in response to specific environmental triggers such as pH changes, temperature fluctuations, or the presence of bacterial enzymes. These advanced coatings can remain dormant until needed, releasing antibacterial agents only when bacterial contamination is detected. This targeted approach minimizes unnecessary use of antimicrobial agents, reduces the risk of developing bacterial resistance, and extends the effective lifetime of the coating for applications in medical implants, wound dressings, and high-risk surfaces.Expand Specific Solutions
Key Industry Players in Antibacterial Medical Textiles
The antibacterial coatings for medical textiles market is in a growth phase, driven by increasing healthcare-associated infections and demand for advanced medical products. The global market is projected to expand significantly, with major players adopting different competitive strategies. Leading companies like BASF Corp. and Microban Products Co. have established strong market positions through extensive R&D capabilities and broad product portfolios. Academic institutions including MIT, Texas A&M, and Beihang University are advancing research in this field. Emerging players such as Intrinsiq Materials and Biomed Protect are focusing on innovative nanoparticle-based solutions, while Asian manufacturers like Luolai Lifestyle Technology and Shanghai Haier Medical Technology are gaining market share through cost-effective production capabilities and regional distribution networks.
Covidien Pte Ltd.
Technical Solution: Covidien (now part of Medtronic) has pioneered advanced antibacterial coating technologies for medical textiles through their ChloraShield™ and BioGuard™ platforms. Their approach combines chlorhexidine-based compounds with proprietary binding agents that create durable antimicrobial protection on surgical drapes, gowns, and wound dressings. The technology employs a dual-action mechanism where the active ingredients both repel microbial adhesion and actively eliminate bacteria that contact the textile surface. Their patented process incorporates antimicrobial agents at the molecular level within the textile structure, creating a reservoir effect that provides sustained release of active compounds over extended periods. Clinical studies have demonstrated that Covidien's coated textiles can reduce surgical site infection rates by up to 40% compared to standard materials. Their manufacturing process ensures uniform distribution of antimicrobial agents throughout the textile substrate, avoiding the inconsistent protection common in spray-on or post-treatment applications. The company has also developed specialized testing protocols that simulate clinical use conditions to verify long-term antimicrobial efficacy under real-world conditions.
Strengths: Extensive clinical validation with documented infection reduction outcomes; seamless integration with existing medical textile manufacturing processes; comprehensive regulatory approvals across major healthcare markets. Weaknesses: Higher production costs compared to standard medical textiles; potential for antimicrobial resistance development with chlorhexidine-based technologies; limited efficacy against certain fungal species and bacterial spores.
BASF Corp.
Technical Solution: BASF has developed a sophisticated portfolio of antimicrobial solutions for medical textiles under their HyGentic® platform. Their approach leverages polymer chemistry expertise to create antimicrobial coatings that bond permanently to textile fibers at the molecular level. BASF's technology utilizes quaternary ammonium compounds (QACs) combined with proprietary silane chemistry that creates covalent bonds with textile substrates, resulting in exceptional durability through repeated laundering and sterilization cycles. Their antimicrobial mechanism involves disrupting bacterial cell membranes through positively charged molecular structures that attract and rupture negatively charged microbial cells. BASF has also pioneered controlled-release technologies that maintain optimal antimicrobial concentration at the textile surface over extended periods. Their advanced formulations incorporate biocompatible polymers that minimize skin irritation while maximizing antimicrobial efficacy. Laboratory testing has demonstrated >99.99% reduction in common hospital pathogens including MRSA and C. difficile within 2 hours of contact. BASF's manufacturing process allows for application during various stages of textile production, offering flexibility for different medical textile applications from surgical gowns to patient bedding.
Strengths: Exceptional durability with antimicrobial protection lasting through 100+ industrial washing cycles; versatile application methods compatible with various textile manufacturing processes; broad-spectrum efficacy against both gram-positive and gram-negative bacteria. Weaknesses: Higher initial implementation costs compared to conventional treatments; potential environmental concerns with some quaternary ammonium compounds; more complex integration process requiring specialized equipment for optimal performance.
Core Antimicrobial Mechanisms & Patent Analysis
Antibacterial coating composition comprising organic acid and antibacterial non-woven fabric for medical use
PatentActiveKR1020220160468A
Innovation
- The antibacterial coating composition combines polymer resin with organic acids and/or plant extracts as antibacterial substances, providing a natural antibacterial approach without synthetic chemicals.
- The antibacterial non-woven fabric includes a liquid substance absorbent component that prevents contamination by absorbing body fluids, creating a dual-function medical textile.
- The coating provides homogeneous dispersibility of antibacterial agents while maintaining good adhesion to the base sheet and skin-friendly properties.
Antimicrobial coatings
PatentWO2020035483A1
Innovation
- An antimicrobial liquid crystal composition comprising amphiphilic lipids, antimicrobial agents, and water that forms stable liquid crystals at room temperature, providing sustained and adhesive antimicrobial properties without requiring additional surfactants or polymers, and can be adapted by stimuli like humidity and pH to enhance antimicrobial efficacy.
Regulatory Compliance & Safety Standards
The regulatory landscape for antibacterial coatings in medical textiles is complex and multifaceted, requiring manufacturers to navigate numerous standards across different jurisdictions. In the United States, the Food and Drug Administration (FDA) classifies antibacterial-coated medical textiles based on their intended use and risk profile, with most falling under Class I or II medical devices. Products making specific antimicrobial claims must undergo rigorous testing protocols to substantiate efficacy claims while demonstrating safety.
The European Union's regulatory framework centers around the Medical Device Regulation (MDR 2017/745), which imposes stringent requirements for clinical evaluation, post-market surveillance, and technical documentation. Additionally, the Biocidal Products Regulation (BPR) governs antimicrobial substances incorporated into medical textiles, requiring comprehensive risk assessments and authorization processes for active ingredients.
ISO standards play a crucial role in establishing globally recognized testing methodologies and quality management systems. ISO 10993 series specifically addresses biocompatibility evaluation of medical devices, while ISO 20743 provides standardized methods for determining antibacterial activity in textile products. These standards ensure consistency in testing procedures and facilitate international market access.
Environmental considerations have gained prominence in regulatory frameworks, with restrictions on certain biocides under REACH (Registration, Evaluation, Authorization and Restriction of Chemicals) in Europe and similar regulations worldwide. Sustainable alternatives must meet both antimicrobial efficacy requirements and environmental safety standards, creating additional compliance challenges for manufacturers.
Safety assessment protocols typically include cytotoxicity testing, sensitization studies, irritation assessments, and systemic toxicity evaluations. Long-term leaching studies are particularly important for determining the stability of antibacterial agents in various clinical environments and their potential for unintended exposure to patients or healthcare workers.
Recent regulatory trends indicate a shift toward harmonization of international standards, though significant regional differences persist. The emergence of novel nanomaterial-based antibacterial coatings has prompted regulatory bodies to develop specific guidance documents addressing unique safety considerations associated with these technologies, including potential for nanoparticle migration and long-term bioaccumulation risks.
Compliance documentation requirements have become increasingly comprehensive, necessitating detailed technical files that include risk management reports, clinical evaluation data, and post-market surveillance plans. Manufacturers must maintain vigilance regarding regulatory updates, as standards continue to evolve in response to emerging technologies and safety concerns in the rapidly advancing field of antimicrobial medical textiles.
The European Union's regulatory framework centers around the Medical Device Regulation (MDR 2017/745), which imposes stringent requirements for clinical evaluation, post-market surveillance, and technical documentation. Additionally, the Biocidal Products Regulation (BPR) governs antimicrobial substances incorporated into medical textiles, requiring comprehensive risk assessments and authorization processes for active ingredients.
ISO standards play a crucial role in establishing globally recognized testing methodologies and quality management systems. ISO 10993 series specifically addresses biocompatibility evaluation of medical devices, while ISO 20743 provides standardized methods for determining antibacterial activity in textile products. These standards ensure consistency in testing procedures and facilitate international market access.
Environmental considerations have gained prominence in regulatory frameworks, with restrictions on certain biocides under REACH (Registration, Evaluation, Authorization and Restriction of Chemicals) in Europe and similar regulations worldwide. Sustainable alternatives must meet both antimicrobial efficacy requirements and environmental safety standards, creating additional compliance challenges for manufacturers.
Safety assessment protocols typically include cytotoxicity testing, sensitization studies, irritation assessments, and systemic toxicity evaluations. Long-term leaching studies are particularly important for determining the stability of antibacterial agents in various clinical environments and their potential for unintended exposure to patients or healthcare workers.
Recent regulatory trends indicate a shift toward harmonization of international standards, though significant regional differences persist. The emergence of novel nanomaterial-based antibacterial coatings has prompted regulatory bodies to develop specific guidance documents addressing unique safety considerations associated with these technologies, including potential for nanoparticle migration and long-term bioaccumulation risks.
Compliance documentation requirements have become increasingly comprehensive, necessitating detailed technical files that include risk management reports, clinical evaluation data, and post-market surveillance plans. Manufacturers must maintain vigilance regarding regulatory updates, as standards continue to evolve in response to emerging technologies and safety concerns in the rapidly advancing field of antimicrobial medical textiles.
Environmental Impact & Biocompatibility Assessment
The environmental impact of antibacterial coatings for medical textiles represents a critical consideration in their development and application. Traditional antimicrobial agents such as silver nanoparticles, triclosan, and quaternary ammonium compounds have demonstrated efficacy against pathogens but raise significant environmental concerns. These substances can leach into wastewater during manufacturing processes and laundering cycles, potentially disrupting aquatic ecosystems and contributing to antimicrobial resistance development in environmental bacteria.
Recent life cycle assessments of silver-based antimicrobial textiles indicate that their environmental footprint extends beyond production to disposal phases. Studies have documented bioaccumulation of silver nanoparticles in aquatic organisms, with potential cascading effects through food chains. The persistence of these antimicrobial agents in the environment necessitates careful evaluation of their long-term ecological impacts.
Biocompatibility assessment constitutes another crucial dimension in evaluating antibacterial coatings for medical textiles. Medical textiles directly contact human skin and tissues, requiring rigorous testing protocols to ensure safety. ISO 10993 standards provide a comprehensive framework for biological evaluation, including cytotoxicity, sensitization, irritation, and systemic toxicity assessments. Recent studies indicate that while many antimicrobial agents effectively eliminate pathogens, they may simultaneously exhibit cytotoxic effects on human cells at similar concentrations.
The biocompatibility profile varies significantly among different coating technologies. Natural antimicrobial compounds such as chitosan and plant-derived extracts generally demonstrate superior biocompatibility compared to synthetic alternatives. However, their efficacy profiles often present limitations that necessitate careful formulation strategies to achieve optimal performance without compromising safety.
Emerging research focuses on developing environmentally sustainable and biocompatible alternatives. Biodegradable polymers incorporating natural antimicrobial agents show promising results in preliminary assessments. Additionally, immobilization techniques that permanently bind antimicrobial agents to textile surfaces minimize leaching concerns while maintaining antimicrobial efficacy. These approaches potentially address both environmental and biocompatibility challenges simultaneously.
Regulatory frameworks increasingly emphasize environmental impact and biocompatibility considerations. The European Union's REACH regulation and the FDA's biocompatibility guidelines significantly influence development pathways for antibacterial medical textiles. Manufacturers must now demonstrate not only antimicrobial efficacy but also environmental safety and biocompatibility through standardized testing protocols before market approval.
Recent life cycle assessments of silver-based antimicrobial textiles indicate that their environmental footprint extends beyond production to disposal phases. Studies have documented bioaccumulation of silver nanoparticles in aquatic organisms, with potential cascading effects through food chains. The persistence of these antimicrobial agents in the environment necessitates careful evaluation of their long-term ecological impacts.
Biocompatibility assessment constitutes another crucial dimension in evaluating antibacterial coatings for medical textiles. Medical textiles directly contact human skin and tissues, requiring rigorous testing protocols to ensure safety. ISO 10993 standards provide a comprehensive framework for biological evaluation, including cytotoxicity, sensitization, irritation, and systemic toxicity assessments. Recent studies indicate that while many antimicrobial agents effectively eliminate pathogens, they may simultaneously exhibit cytotoxic effects on human cells at similar concentrations.
The biocompatibility profile varies significantly among different coating technologies. Natural antimicrobial compounds such as chitosan and plant-derived extracts generally demonstrate superior biocompatibility compared to synthetic alternatives. However, their efficacy profiles often present limitations that necessitate careful formulation strategies to achieve optimal performance without compromising safety.
Emerging research focuses on developing environmentally sustainable and biocompatible alternatives. Biodegradable polymers incorporating natural antimicrobial agents show promising results in preliminary assessments. Additionally, immobilization techniques that permanently bind antimicrobial agents to textile surfaces minimize leaching concerns while maintaining antimicrobial efficacy. These approaches potentially address both environmental and biocompatibility challenges simultaneously.
Regulatory frameworks increasingly emphasize environmental impact and biocompatibility considerations. The European Union's REACH regulation and the FDA's biocompatibility guidelines significantly influence development pathways for antibacterial medical textiles. Manufacturers must now demonstrate not only antimicrobial efficacy but also environmental safety and biocompatibility through standardized testing protocols before market approval.
Unlock deeper insights with Patsnap Eureka Quick Research — get a full tech report to explore trends and direct your research. Try now!
Generate Your Research Report Instantly with AI Agent
Supercharge your innovation with Patsnap Eureka AI Agent Platform!